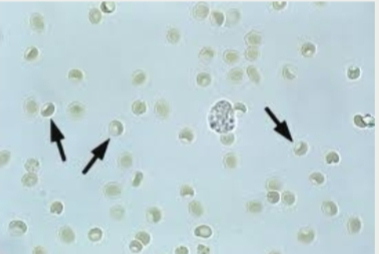
term image

1/188
Looks like no tags are added yet.
Name | Mastery | Learn | Test | Matching | Spaced | Call with Kai |
|---|
No analytics yet
Send a link to your students to track their progress

roundworm
what is the scientific name for roundworm
toxocara

hookworm
what is the scientific name for hookworm
Ancylostoma

Strongyles

whipworm
what is the scientific name for whipworm
Trichuris

tapeworm
what is the scientific name for tapeworm
Dipylidium caninum

Coccidia
what is the scientific name for coccidia
Cystoisospora
STRAINING TO URINATE
OLIGURIA
INCREASED URINATION
POLYURIA
INCREASED WATER CONSUMPTION
POLYDIPSIA
NO URINE NOTICED
ANURIA
term for a normal specific gravity
isosthenuria
term for an increased specific gravity
hypersthenuria
term for a decreased specific gravity
hyposthenuria
term given to presence of protein in urine
Proteinuria
term given to presence of glucose in urine
Glucosuria
term given to presence of ketones in urine
Ketonuria
term given to presence of bilirubin in urine
Bilirubinuria
term given to presence of crystals in urine
Crystalluria
term given to presence of WBC in urine
Pyuria or leukouria
term for presence of fat in urine
Lipuria
intact RBC is termed
Hematuria
ghost cells indicate
Hemoglobinuria
name for urinary stones or bladder stones
urolith

Struvite
what pH type is struvite found in
all three
what is the most common crystal
struvite

calcium oxalate dihydrate

calcium oxalate monohydrate (picket fence slat)

calcium oxalate monohydrate (dumb bell shape)
what is calcium oxalate monohydrate found in
anti-freeze poisoning (ethylene glycol)

calcium carbonate
what pH is calcium carbonate found
neutral or alkaline
what animals are calcium carbonate crystals common in
rabbits and horses

cystine crystals
what pH are cystine crystals found in
acidic

uric acid

Ammonium Biurate

bilirubin

amorphous material

tyrosine
casts dissolve in what type of urine?
alkaline

hyaline cast
what is a hyaline cast composed on
protein only

granular cast

epithelial cast

WBC cast

RBC casts

waxy cast

fatty cast

renal tubular epithelial cell

transitional epithelial cell
where are the transitional epithelial cells located
Bladder, ureters, renal pelvis, proximal urethra

squamous epithelial cell
what do squamous epithelial cells line
Distal urethra, vagina, vulva, prepuce
what are round shaped bacteria called
cocci
what are rod shaped bacteria called
bacilli
RBC

WBC
how soon after collection should urine be analyzed
30 minutes
how long does refrigeration preserve urine
6-12 hours
dog and cat normal urine production
20–40 mL/kg/day
What imparts color in urine?
UROCHROME PIGMENTS
what does an ammonia odor indicate
cystitis or urease bacteria
what does a sweet/fruit/alcohol odor indicate
ketones
what does specific gravity represent
Kidney’s ability to concentrate/dilute urine
pH for Herbivores
Alkaline: 7.0-8.5
pH of carnivore
acidic: 6.0-7.0
pH of omnivores
either alkaline or acidic
How does room temperature affect pH?
increases
What is the biggest determining factor that will affect pH?
diet
How are ketones formed?
Fat metabolism
Sediment red + supernatant clear indicates
Hematuria
Add ammonium sulfate + re-centrifuge, Supernatant becomes clear
Hemoglobinuria
Add ammonium sulfate + re-centrifuge, Supernatant stays red/brown
Myoglobinuria
what are other names for struvite crystals
triple phosphate or magnesium ammonium phosphate
A urine sample that is pale yellow in color and is associated with which on the following
polyuria

Squamous epithelial cells

Transitional epithelial cells

Hyaline Cast

hyaline cast

RBC cast

Epithelial Cast

Waxy Cast

Fatty cast

Ammonium biurate crystal

Bilirubin

Calcium Carbonate

Calcium oxalate dihydrate

Calcium Oxalate monohydrate

Cystine Crystal

Struvite

Uric Acid

Fat Droplets

sperm

bacteria